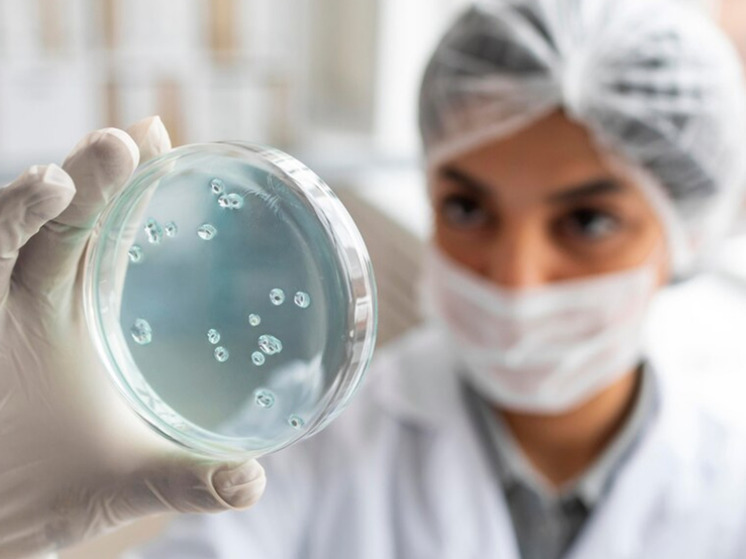

Вирусологи бьют тревогу из-за угрозы новой пандемии
Человечество сталкивается с новой угрозой странной пандемии, предупреждают ученые. Древние вирусы, замороженные в вечной мерзлоте Арктики, могут однажды высвободиться из-за потепления климата Земли и вызвать крупную вспышку заболеваний, говорят они.
Ученые предупреждают, что арктические зомби-вирусы могут спровоцировать новую ужасающую пандемию, пишет The Observer.
Штаммы этих микробов Мафусаила – или зомби-вирусов, как их еще называют, – уже были выделены исследователями, которые выразили опасения, что новая глобальная чрезвычайная медицинская ситуация может быть вызвана — не новой для науки болезнью, а болезнью из далекого прошлого.
В результате ученые приступили к планированию арктической сети мониторинга, которая позволила бы выявлять ранние случаи заболевания, вызываемого древними микроорганизмами. Кроме того, она обеспечила бы карантин и квалифицированную медицинскую помощь инфицированным людям в попытке сдержать вспышку и предотвратить выезд инфицированных людей из региона.
“На данный момент анализ угроз пандемии сосредоточен на болезнях, которые могут возникнуть в южных регионах и затем распространиться на север, — рассказывает генетик Жан-Мишель Клавери из Университета Экс-Марсель. – Напротив, мало внимания уделялось вспышке, которая может возникнуть на Крайнем Севере, а затем распространиться на юг, – и я считаю, что это недосмотр. Там есть вирусы, которые потенциально могут заразить людей и вызвать новую вспышку заболевания”.
Эту точку зрения поддерживает вирусолог Марион Купманс из медицинского центра Erasmus в Роттердаме: “Мы не знаем, какие вирусы скрываются там, в вечной мерзлоте, но я думаю, что существует реальный риск того, что может найтись вирус, способный вызвать вспышку заболевания – скажем, древней формы полиомиелита. Мы должны предположить, что нечто подобное могло произойти”.
В 2014 году Жан-Мишель Клавери возглавлял команду ученых, которые выделили живые вирусы в Сибири и показали, что они по-прежнему могут заражать одноклеточные организмы, даже несмотря на то, что они были погребены в вечной мерзлоте в течение тысяч лет. Дальнейшие исследования, опубликованные в прошлом году, выявили существование нескольких различных вирусных штаммов из семи разных мест в Сибири и показали, что они могут инфицировать культивируемые клетки. Одному образцу вируса, как определили ученые, насчитывалось 48 500 лет.
“Вирусы, которые мы выделили, были способны заражать только амеб и не представляли опасности для людей, — отмечает Клавери. – Однако это не означает, что другие вирусы, которые в настоящее время заморожены в вечной мерзлоте, не могут вызывать заболевания у людей. Мы идентифицировали геномные следы поксвирусов и герпесвирусов, которые, например, являются хорошо известными патогенами человека”.
Вечная мерзлота покрывает пятую часть северного полушария и состоит из почвы, которая долгое время хранилась при температурах ниже нуля, пишет The Observer. Ученые обнаружили, что некоторые слои оставались замороженными в течение сотен тысяч лет.
“Ключевым моментом вечной мерзлоты является то, что в ней холодно, темно и не хватает кислорода, что идеально подходит для сохранения биологического материала, — рассказал Клавери изданию The Observer на прошлой неделе. – Вы могли бы поместить йогурт в вечную мерзлоту, и он все еще мог бы оставаться съедобным 50 000 лет спустя”.
Но вечная мерзлота в мире меняется, обращает внимание The Observer. Верхние слои основных запасов планеты – в Канаде, Сибири и на Аляске – тают, поскольку изменение климата непропорционально сильно влияет на Арктику. По данным метеорологов, регион нагревается в несколько раз быстрее, чем средние темпы увеличения глобального потепления.
Однако непосредственный риск представляет не непосредственное таяние вечной мерзлоты, добавил Клавери: “Опасность исходит от другого воздействия глобального потепления: исчезновения арктического морского льда. Это позволяет увеличить судоходство, трафик и промышленное развитие в Сибири. Планируются масштабные операции по добыче полезных ископаемых, в ходе которых в глубине вечной мерзлоты будут пробурены огромные скважины для добычи нефти и руд. Эти операции приведут к высвобождению огромного количества патогенных микроорганизмов, которые все еще процветают там. Шахтеры будут заходить внутрь и вдыхать вирусы. Последствия могут быть катастрофическими”.
Этот момент подчеркивается Марион Купманс: “Если вы посмотрите на историю эпидемических вспышек, одной из ключевых движущих сил были изменения в землепользовании. Вирус Нипа был распространен плодовыми летучими мышами, которых люди изгнали из мест их обитания. Аналогичным образом, оспа обезьян была связана с распространением урбанизации в Африке. И это то, что мы будем наблюдать в Арктике: полное изменение в землепользовании, и это может быть опасно, как мы видели в других местах”.
Ученые полагают, что вечная мерзлота – на самых глубоких ее уровнях – может содержать вирусы возрастом до миллиона лет, и поэтому они будут намного старше нашего собственного вида, который, как считается, появился около 300 000 лет назад.
“Наша иммунная система, возможно, никогда не контактировала с некоторыми из этих микробов, и это вызывает еще одно беспокойство, – отмечает Клавери. – Сценарий, при котором неизвестный вирус, однажды заразивший неандертальца, вернется к нам, хотя и маловероятен, стал реальной возможностью”.
По этой причине Клавери и другие специалисты работают с UArctic, Университетом Арктики – международной образовательной сетью в полярном регионе – над планами создания карантинных объектов и предоставления медицинской экспертизы, которая могла бы выявить ранние случаи заболевания и лечить их на месте, чтобы попытаться сдержать инфекцию: “Сейчас мы сталкиваемся с ощутимой угрозой, и нам нужно быть готовыми справиться с ней. Все очень просто”.